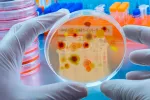
Estos son los 19 hongos que más amenazan la salud pública según la OMS 19 hongos que amenazan la salud mundial

Fibromialgia: unas gafas verdes reducen la ansiedad por el dolor

24/10/2022
La fibromialgia es una enfermedad reumática de causa desconocida y difícil de diagnosticar que sufren millones de personas, la mayoría de ellas mujeres, y que provoca grandes dolores a quien lo sufre, con la consecuente sensación de ansiedad. Estos dolores según un estudio presentado en la Reunión Anual de 2020 de ANESTHESIOLOGY, podrían reducirse gracias a unas gafas.
Se trata de unas gafas especiales que tienen cristales verdes, llevar este tipo de anteojos durante varias horas cada día ha demostrado ser eficaz ala hora de reducir la ansiedad vinculada al dolor, un hecho que podría ayudar a controlar el dolor intenso y crónico de la fibromialgia y otras personas con dolor crónico sin necesidad de utilizar opioides, unos fármacos que pueden crear dependencia.
Y es que el dolor y la ansiedad asociados con esta condición comparten mecanismos biológicos similares. Además, el miedo al dolor en las pacientes exacerba su ansiedad y puede llevarles a recurrir al uso de opioides.
“Nuestra investigación encontró que ciertas longitudes de onda de luz verde estimulan las vías en el cerebro que ayudan a controlar el dolor. Existe una necesidad urgente de tratamientos adicionales para reducir el uso de opioides entre los pacientes con fibromialgia y otros tipos de dolor crónico, y los anteojos verdes podrían proporcionar una opción fácil de usar y sin medicamentos”, ha explicado Padma Gulur, autora principal del estudio.
El espectro de luz verde activa la zona del cerebro vinculada al dolor
Para llegar a estas conclusiones, los investigadores analizaron a 34 pacientes con fibromialgia, 10 de ellos llevaron gafas con cristales azules, 12 transparentes y 12 verdes, durante cuatro horas al día durante dos semanas, después se les entrevistó para conocer su grado de dolor y ver si los anteojos habían provocado cambios.
Los resultados mostraron que aquellos que utilizaron las gafas verdes tenían hasta cuatro veces más probabilidades de presentar una reducción en la ansiedad que el resto de grupos, que no mostraron cambios. Tanto notaron la diferencia los participantes que llevaron las gafas verdes que pidieron seguir usándolas en su día a día después de la investigación.
Los participantes que llevaron las gafas con los cristales verdes tuvieron cuatro veces más probabilidades de reducir su ansiedad por dolor en la fibromialgia
“Descubrimos que, aunque sus puntajes de dolor permanecieron iguales, aquellos que usaban anteojos verdes usaban menos opioides, lo que demuestra que su dolor estaba controlado adecuadamente. Recomendaríamos el tratamiento de anteojos verdes para las personas con fibromialgia y estamos estudiando pacientes con otras afecciones de dolor crónico para determinar si sería beneficioso”, explica Gulur.
Según han explicado los autores del estudio, el dolor y la ansiedad tienen mecanismos biológicos compartidos y similares, además, las personas que tienen miedo al dolor pueden presentar unos niveles más altos de ansiedad, lo que suele derivar en una mayor necesidad de consumir opioides.
Las gafas con las que se han hecho las pruebas del estudio no son simplemente unos anteojos con cristales verdes, sino que están especialmente creadas para filtrar una longitud de onda específica en el espectro de luz verde, que puede activar la parte del cerebro que controla el dolor.
Actualizado: 5 de mayo de 2023